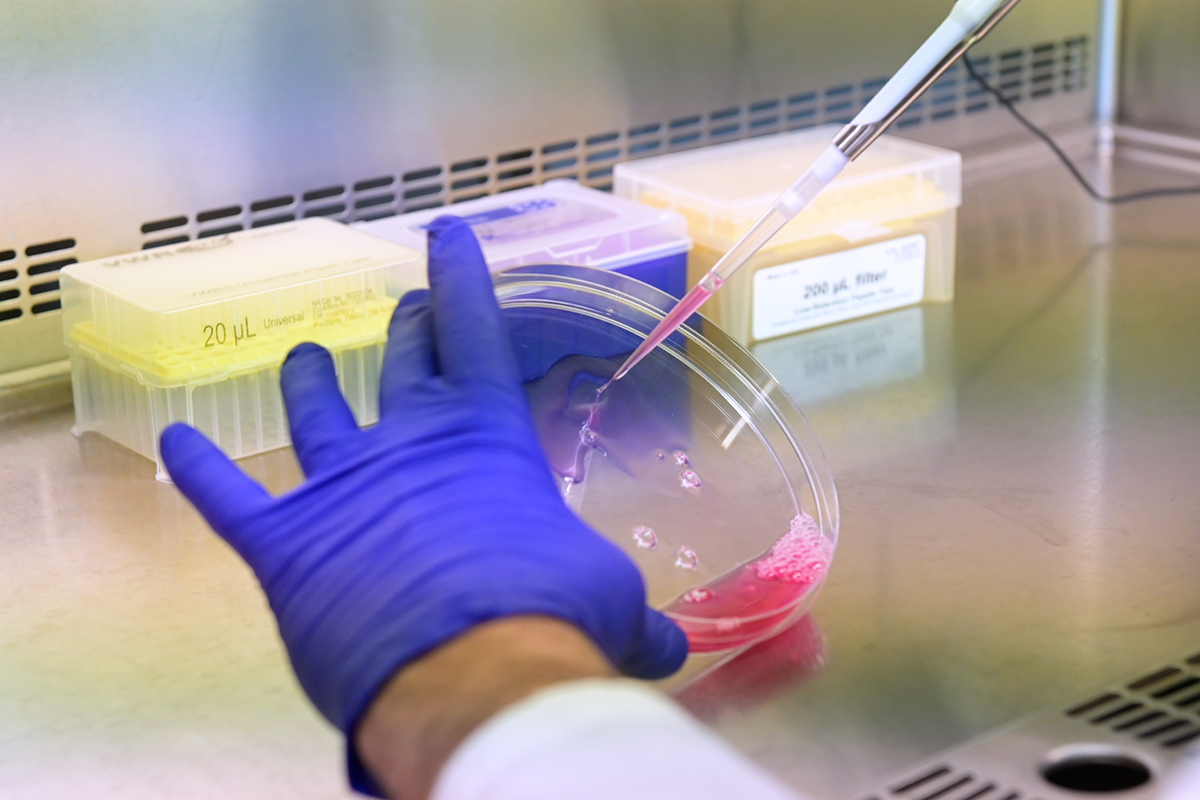

Search Website
QUICK LINKS:
Biochemistry
Our graduate program explores the study of living things at the molecular level, and the interconnected fields that address how science understands and treats human diseases.
Biochemistry
Our graduate program explores the study of living things at the molecular level, and the interconnected fields that address how science understands and treats human diseases.
Biochemistry
Our graduate program explores the study of living things at the molecular level, and the interconnected fields that address how science understands and treats human diseases.
About the program
Biochemistry lets you explore a variety of areas, including human genetics, genome dynamics, epigenetics, and gene expression. Or focus on protein structure and function, proteomics and cellular signaling. You can also delve into computational approaches and bioinformatics, which are becoming an essential part of biochemical research. You can also investigate the technologies driving the exciting advancements in synthetic biology.
- Program name: Biochemistry
- Degree level: MSc, PhD
- Program duration, deadlines & requirements: See program details
- Contact: Megan Luckovitch mluckovi@uwo.ca
- Website: Biochemistry
Reasons to study
Dynamic field of study
Understand the molecular basis of disease and use this understanding as the foundation for experimentation and discovery.

Transferable research skills
Learn how to design, perform and analyze experiments, critically evaluate information, communicate effectively and apply research to real-world problems.
Fields of research
Genome dynamics epigenetics and gene expression
Human genetics and clinical biochemistry
Signal transduction and intracellular communication
Macromolecular structure and dynamics
Proteomics
Bioinformatics
Program details
Duration
- Six terms (Two years)
- Six terms (Two years) - accelerated MSc*
Application deadlines
Domestic
- October 1 (for January intake)
- February 1 (for May start and first-round considerations for September intake)
- June 1 (for September intake)
International
- July 1 (for January start)
- November 1 (for May start)
- March 1 (for September start)
Requirements
Educational background:
- BSc in biochemistry, biology, genetics, chemistry, cell biology, microbiology, physiology or closely related disciplines.
Grade requirement:
- Minimum 78% GPA in undergraduate degree.
English Language Proficiency (if your first language is not English):
- TOEFL: 250 (computer-based), 90 (iBT, no section below 22).
- IELTS: 6.5 out of 9.
- Fanshawe College ESL Program: Level 5, advanced academic preparation, minimum 80% in each component.
Duration
- Fifteen terms (five years) - Direct entry PhD; Transfer MSc to PhD
- Twelve terms (four years) - PhD (learners entering with master’s degree)
Application deadlines
Domestic
- October 1 (for January intake)
- February 1 (for May start and first-round considerations for September intake)
- June 1 (for September intake)
International
- July 1 (for January start)
- November 1 (for May start)
- March 1 (for September start)
Requirements
Educational background:
- BSc in biochemistry, biology, genetics, chemistry, cell biology, microbiology, physiology or closely related disciplines.
Grade requirement:
- Minimum 78% average in the undergraduate degree or master's degree.
English Language Proficiency (if your first language is not English):
- TOEFL: 250 (computer-based), 90 (iBT, no section below 22).
- IELTS: 6.5 out of 9.
- Fanshawe College ESL Program: Level 5, advanced academic preparation, minimum 80% in each component.
Apply now via Western's School of Graduate and Postdoctoral Studies
Plan your finances
What it costs
Expenses usually include tuition, fees, housing, food and many other necessities.
Find your tuition and fees in the fee schedules available through the Office of the Registrar.
Support available
As a thesis-based graduate learner, you may be eligible to receive funding.
Check out the funding package for Biochemistry.
Plan ahead
Managing your finances, time, and overall wellness are critical to your academic success.
Use the Graduate Student Affordability Calculator to estimate how much money you will need to pay for your tuition, fees, housing, food, and other necessities for a 12-month (three-term) academic year.
Career resources & opportunities
As a Western graduate student, you have access to an abundance of quality professional development opportunities, which make it simple for you to self-direct your learning and development, maximize the value of your degree and ease your career transition.
Own Your Future
Upskilling graduates for success
Internship program
Career opportunities may include
- Post-doctoral research and advanced training
- Professional training: medicine, nursing, law, business, dentistry, teaching, pharmacy
- Research associate or technician (academic)
- Industrial research scientist or technician
- Intellectual property specialist
- Sales/account representative
- Clinical trials coordinator
- Lab or project coordinator, Facility manager
- Business and management consulting
- Government policy and research: Health Canada, Agriculture Canada
In their words

Brianna Gonga-Cavé, PhD Biochemistry, and 2025.
PhD Growth: Research, Communication, and Career Preparedness
Have questions? Connect with us!
Contact our program coordinator for more information on the program and finding a supervisor, or get your questions answered.
Megan Luckovitch
Graduate Program Administrator
megan.luckovitch@schulich.uwo.ca
Your life at Western
Campus life
Connect, explore, and thrive on our close-knit campus.
Campus tours
Campus tours are available for anyone interested in attending Western.
About London, Ontario
Discover all that Western and London have to offer.